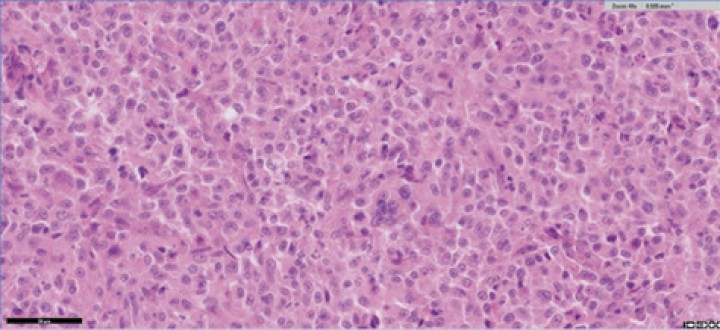

Sarcoma histiocítico ocular felino
Feline ocular histiocytic sarcoma
Mª T. Artacho-Burgos, A. I. Raya-Bermúdez
Contacto: oncologia@sosanimal.es
Resumen
Se presenta el caso de un sarcoma histiocítico ocular en una gata europea de pelo corto, hembra esterilizada, de ocho años de edad, que no mostraba evidencia de afectación a otras estructuras en el momento del diagnóstico inicial. La paciente fue sometida a un protocolo completo de estadiaje clínico, incluyendo estudios de imagen y análisis complementarios, tras lo cual se planificó una enucleación como tratamiento primario. El examen histopatológico del tejido extirpado, junto con el estudio inmunohistoquímico utilizando marcadores específicos (CD3, CD79a y CD204), permitió confirmar de forma concluyente el diagnóstico de sarcoma histiocítico. Aunque se consideró la instauración de un tratamiento con quimioterapia adyuvante, que finalmente fue rechazado por la tutora, la paciente desarrolló signos neurológicos agudos dos semanas después de la cirugía, caracterizados por alteraciones compatibles con un síndrome vestibular central, posiblemente por diseminación a través del nervio óptico. Ante la rápida progresión del cuadro neurológico, el deterioro significativo del estado general y el compromiso severo de la calidad de vida, se optó por realizar una eutanasia humanitaria, en consenso con los tutores.
Palabras clave: sarcoma histiocítico, felino, ocular.
Clin Vet Peq Anim 2025, 45 (4): 279-285
Summary
A case of ocular histiocytic sarcoma is presented in an eight-year-old spayed female European Shorthair cat, which showed no evidence of involvement of other structures at the time of initial diagnosis. The patient underwent a full clinical staging protocol, including imaging studies and additional diagnostic tests, after which ocular enucleation was planned as the primary treatment. Histopathological examination of the excised tissue, along with immunohistochemical analysis using specific markers (CD3, CD79a, and CD204), conclusively confirmed the diagnosis of histiocytic sarcoma. Although adjuvant chemotherapy was considered, it was ultimately declined by the guardian. Two weeks after surgery, the patient developed acute neurological signs characterized by symptoms consistent with central vestibular syndrome, possibly due to dissemination via the optic nerve. Given the rapid progression of the neurological condition, significant deterioration of the general health status, and severe compromise of quality of life, humane euthanasia was performed in agreement with the guardians.
Keywords: histiocytic sarcoma, feline, ocular.
Clin Vet Peq Anim 2025, 45 (4): 279-285

La presencia de este logo en un artículo de la revista indica que se publicará un examen sobre el mismo en la plataforma AVEPA Elearning. Su resolución aporta 0,15 créditos dentro del sistema de acreditaciones de especialidades veterinarias de AVEPA.
Introducción
En gatos, las neoplasias orbitarias comprenden una variedad de tipos tumorales, siendo los tumores de células redondas los más frecuentes (47 %), seguidos por los tumores epiteliales (38-40 %), mesenquimales (14 %) y de origen neurológico (1-2 %). Entre ellos, el linfoma y el carcinoma de células escamosas son los más prevalentes. No obstante, es importante considerar que, en perros y gatos con enfermedad orbitaria, los procesos inflamatorios, particularmente la celulitis orbital, pueden ser más comunes que las neoplasias.1-2
En cuanto a las neoplasias histiocíticas, son considerablemente más raras en gatos que en perros; sin embargo, hasta la fecha se han documentado tres formas distintas de neoplasias histiocíticas en esta especie. Estas incluyen el sarcoma histiocítico (SH), que comparte características morfológicas y biológicas de la forma canina; la histiocitosis progresiva felina, una forma cutánea de neoplasia histiocítica que, aunque tiene un comportamiento indolente, presenta un curso progresivo a lo largo del tiempo; y la histiocitosis de células de Langerhans, que típicamente se presenta como una enfermedad localizada en el pulmón. Estas variantes, aunque menos frecuentes en gatos, destacan la diversidad de manifestaciones de las neoplasias histiocíticas en esta especie, lo que subraya la importancia de un diagnóstico preciso y oportuno.3
Según el conocimiento del autor y tras una revisión bibliográfica, solo se ha documentado un caso previo de SH ocular en la especie felina, lo que convierte al presente informe en el segundo caso descrito de SH ocular localizado sin evidencia de metástasis en las pruebas realizadas. Este hallazgo refuerza la rareza de esta presentación, destacando aún más la singularidad del caso y la importancia de reconocer las diferentes manifestaciones del SH en felinos.4
Caso clínico
Se presentó en consulta una gata europea de pelo corto, hembra esterilizada, de ocho años de edad, que acudió por la aparición de una masa de gran tamaño en la región ocular derecha.
Durante la exploración, se observó una masa localizada en la región periorbitaria derecha, con extensión hacia la órbita, lo que provocaba el desplazamiento completo del globo ocular derecho, de tal manera que no fue posible su evaluación directa. La masa medía aproximadamente 4 × 3,5 × 3 cm. La superficie de la masa estaba ulcerada e irregular, con áreas eritematosas y signos de hemorragia reciente. A la palpación, la consistencia era firme, sin secreciones purulentas ni signos clínicos de infección sistémica. El ojo contralateral no presentaba alteraciones visibles (Fig. 1).
Figura 1
Imagen de la paciente en el momento de la consulta.
La exploración física de la paciente se encontraba dentro de los parámetros normales, con temperatura y color de mucosas dentro de los valores de referencia. No se observaron linfadenopatías, la auscultación cardiopulmonar fue adecuada y la evaluación neurológica fue completamente normal, sin hallazgos clínicos relevantes.
Ante esta presentación, se consideraron distintos diagnósticos diferenciales, incluyendo procesos de origen inflamatorio, infeccioso, neoplásico o traumático, siendo necesarios estudios complementarios para el diagnóstico definitivo.
Para realizar un estudio más preciso, se llevó a cabo un hemograma que mostró una anemia no regenerativa, normocítica y normocrómica, junto con una leve neutrofilia y monocitosis. Los parámetros del perfil bioquímico fueron normales (Tablas 1 y 2). Asimismo, se realizó una prueba FIV/FeLV que resultó negativa (Tabla 3).
Los valores en rojo son superiores al intervalo de referencia y los valores en verde son inferiores a dicho intervalo.
La ecografía abdominal no reveló alteraciones significativas, y los órganos y estructuras evaluados se encontraron dentro de la normalidad. Las radiografías torácicas en tres proyecciones no mostraron signos radiológicos significativos, mostrando una imagen del patrón pulmonar, mediastino y silueta cardiaca normales y sin evidencias claras de masas o efusión pericárdica (Fig. 2).
Figura 2
Imágenes radiográficas. (A) Proyección lateral derecha. (B) Proyección ventrodorsal. (C) Proyección lateral izquierda.
Finalmente, se realizó una tomografía computarizada (TC) de cabeza y tórax con el objetivo de identificar posibles metástasis regionales o a distancia, así como para facilitar una adecuada planificación quirúrgica. La TC no evidenció lesiones osteolíticas, linfadenopatías ni signos de diseminación metastásica, incluido el sistema nervioso central. Sin embargo, no fue posible descartar con certeza la invasión del nervio óptico, ya que la masa ocupaba por completo la cuenca orbitaria derecha, incluyendo el espacio retrobulbar y desplazando los vasos sanguíneos en dirección dorsocraneal. Esta extensión dificultó la evaluación precisa de la infiltración del nervio óptico y estructuras vasculares adyacentes. A pesar de ello, los hallazgos confirmaron la localización primaria de la masa en la región ocular derecha y la ausencia de diseminación a otros órganos en el momento del estudio (Figs. 3 y 4).
Figura 3
Imágenes tomográficas (transversal, sagital y coronal) donde se observa la masa de 3,3 × 3,7 × 5 cm (flechas) centrada en el globo ocular derecho, con atenuación de partes blandas y escasa captación periférica de contraste, que ocupa toda la órbita incluyendo el espacio retrobulbar, desplazando estructuras vasculares y con posible invasión del nervio óptico. Se extiende hacia el exterior sin provocar lesiones óseas en las estructuras adyacentes. Imagen cedida por el Hospital Bluecare.
Figura 4
Imagen tomográfica transversa donde, a nivel intracraneal, no se evidencia ninguna lesión intra o extraaxial, no existe desplazamiento de la línea media, ni edema cerebral. La captación de contraste es normal y simétrica. Sin alteraciones meníngeas. Imagen cedida por el Hospital Bluecare.
Se realizó una enucleación, extirpando en bloque el globo ocular derecho, dado que la masa parecía originarse en él o haberlo destruido por completo. No se evidenció invasión ósea ni de los tejidos perioculares, lo que permitió centrar la resección únicamente en el globo ocular. Este procedimiento redujo el tiempo quirúrgico y el riesgo de complicaciones asociadas con procedimientos más extensos.
La muestra fue enviada al laboratorio de anatomía patológica, donde la valoración microscópica de las secciones preliminares del globo ocular reveló células que presentaban contornos bien definidos, con citoplasma abundante de aspecto fibrilar y eosinófilo. Los núcleos eran ovalados, de cromatina granular a finamente punteada y nucléolos centrales prominentes, redondos y de color magenta. Se observaba marcada anisocitosis y anisocariosis, con presencia frecuente de células cariomegálicas y algunas multinucleadas. Se identificaron tres figuras mitóticas en un área de 2,37 mm². Algunas células exhibieron citoplasma con vacuolización prominente. En la masa se evidenciaron focos dispersos de necrosis, caracterizados por material fibrilar eosinófilo y detritos cariorrécticos. Asimismo, los márgenes de la muestra orbitaria estaban libres de células tumorales (Fig. 5).
Figura 5
Imagen histológica donde se observa una proliferación celular con citoplasma eosinófilo fibrilar, núcleos ovalados con cromatina granular y nucléolo prominente. Hay marcada anisocitosis y anisocariosis, presencia de células multinucleadas y cariomegálicas, actividad mitótica moderada (3 mitosis en 2,37 mm²) y focos multifocales de necrosis con restos celulares. H&E 400x. Imagen cedida por laboratorio Vetlab.
En base a las características morfológicas observadas, se consideró que la masa correspondía a un tumor intraocular de células redondas. Dentro de los principales diagnósticos diferenciales se incluyeron el SH y el linfoma. A solicitud del patólogo, se llevó a cabo un panel de inmunohistoquímica empleando los marcadores CD3, CD79a y CD204 con el objetivo de precisar la estirpe celular. El estudio inmunohistoquímico mostró una marcada positividad para CD204 en más del 90 % de las células tumorales, compatible con un fenotipo histiocítico, confirmando el diagnóstico de SH5,6 (Fig. 6).
Figura 6
Imagen marcador CD204. Las células atípicas muestran un marcaje prominente de su membrana citoplásmica y citoplasma con este anticuerpo. Más del 90 % de las células atípicas en sección son positivas. H&E 400x. Imagen cedida por laboratorio Vetlab.
Una vez obtenido este diagnóstico, se propuso iniciar un tratamiento de quimioterapia adyuvante con lomustina oral (10 mg/gato), administrada cada 4 a 6 semanas, ajustada según la tolerancia de la paciente y la aparición de efectos secundarios, especialmente neutropenia.
Sin embargo, dos semanas después de la cirugía, la paciente desarrolló ataxia ambulatoria e inclinación cefálica, signos compatibles con un síndrome vestibular central, posiblemente debido a la diseminación tumoral a través del nervio óptico. Ante este cuadro, la tutora rechazó el tratamiento y los controles propuestos.
Dos meses después, la paciente fue llevada nuevamente a consulta, presentando un deterioro neurológico avanzado, acompañado de anorexia y pérdida de peso significativa. Dada la gravedad del cuadro clínico y en consideración al bienestar de la paciente, se procedió a realizar una eutanasia humanitaria.
El tiempo total de supervivencia fue de 66 días.
Discusión
El SH se caracteriza típicamente por la presencia de un tumor solitario, localizado en una región específica del cuerpo. Sin embargo, cuando el SH se disemina, se denomina "sarcoma histiocítico diseminado", lo que implica la presencia de metástasis a distancia. En casos de progresión rápida de la enfermedad, los sitios primarios y metastásicos pueden volverse clínicamente indistinguibles, lo que dificulta la diferenciación entre un SH diseminado y una histiocitosis maligna. Esta superposición clínica resalta la complejidad del diagnóstico y manejo de los casos avanzados, dado que ambos procesos comparten características patológicas similares, con una diseminación invasiva y un curso clínico agresivo.7
La forma localizada del SH es poco frecuente en gatos; sin embargo, se han documentado casos en otras localizaciones anatómicas, como en el tarso y el puente o plano nasal, con un total de tres gatos afectados, así como un caso adicional en el estómago.3 Este caso clínico representa el segundo informe conocido de un SH ocular localizado en un felino. Este hallazgo subraya la importancia de considerar esta neoplasia en los diagnósticos diferenciales cuando se presenten masas orbitarias o periorbitarias.
Dada la similitud del SH en perros y gatos, se ha planteado la posibilidad de extrapolar ciertos factores pronósticos entre ambas especies. Dentro de estos factores, se ha señalado la importancia del patrón de presentación (localizado frente a diseminado), el recuento plaquetario y la instauración de un tratamiento oncológico activo, ya sea quirúrgico, quimioterápico o combinado. En el ámbito de las alteraciones hematológicas y bioquímicas, diversos estudios han asociado la presencia de anemia, trombocitopenia, hipoalbuminemia e hipoproteinemia con una menor supervivencia global. En el caso clínico que nos ocupa, únicamente se detectó una anemia no regenerativa como hallazgo significativo, sin otras alteraciones.8
El SH puede presentar una amplia variabilidad morfológica, lo que complica en muchos casos la obtención de un diagnóstico definitivo basado únicamente en la histopatología convencional. Esta heterogeneidad celular puede generar confusión con otros tumores de células redondas, particularmente el linfoma, que constituyó uno de los principales diagnósticos diferenciales considerados en el presente caso. En este contexto, la inmunohistoquímica adquiere un papel clave. El marcador CD204, un receptor depurador expresado en macrófagos tisulares, ha demostrado una alta especificidad para identificar células de estirpe histiocítica, permitiendo distinguir el SH de otras neoplasias con morfología superpuesta. En nuestro caso, la fuerte positividad para CD204 en más del 90 % de las células tumorales determinó el diagnóstico de SH.5,6
En otros estudios previos, como el caso descrito de SH ocular, se empleó también el marcador CD18 como herramienta complementaria para confirmar el origen histiocítico del proceso neoplásico.4,9 Sin embargo, CD18 indica únicamente “origen leucocitario” y no es específico para histiocitos. Para un diagnóstico confiable de histiocitosis o SH, debe interpretarse junto con CD204, IBA1 o CD11d, y descartando linajes linfoides mediante CD3, CD79a o CD20.10
El pronóstico del SH es generalmente reservado a desfavorable, principalmente debido a su agresiva biología tumoral y a la rápida progresión clínica que caracteriza esta neoplasia. La literatura disponible describe que las metástasis pueden aparecer en los ganglios linfáticos regionales y que el proceso neoplásico puede extenderse a estructuras adyacentes y a órganos a distancia, incluso en casos inicialmente considerados localizados. En el caso descrito, aunque por decisión de los tutores no se realizó la punción de los ganglios linfáticos, prueba que habría permitido confirmar la ausencia de metástasis, las técnicas de imagen avanzada no revelaron hallazgos compatibles con diseminación metastásica en el momento del diagnóstico. No obstante, la aparición de signos neurológicos como ataxia ambulatoria e inclinación cefálica pocas semanas después de la enucleación sugirió una posible diseminación del proceso tumoral hacia el sistema nervioso central a través del nervio óptico. Esta progresión clínica refuerza el comportamiento infiltrativo y potencialmente invasivo del SH.11
En cuanto al abordaje terapéutico del SH, se han empleado esquemas quimioterápicos basados principalmente en doxorrubicina o lomustina, aunque los resultados clínicos obtenidos han sido, en general, poco alentadores.12,13 En el presente caso, se propuso el uso de lomustina por vía oral, a una dosis de 10 mg/gato, como tratamiento adyuvante posterior a la cirugía, aunque finalmente fue rechazado por la tutora. Este agente alquilante presenta un perfil de toxicidad hematológica relativamente manejable; la incidencia reportada de neutropenia y trombocitopenia de grado III o IV es del 4,1 % y 1,0 %, respectivamente.3-14 Las respuestas al tratamiento suelen ser limitadas, y la supervivencia global tiende a mantenerse por debajo de los seis meses en la mayoría de los casos, debido a la rápida progresión de la enfermedad y su potencial diseminación.11
Una alternativa terapéutica que podría haberse considerado como más eficaz habría sido la combinación de quimioterapia con radioterapia locorregional, especialmente a la luz de los hallazgos histopatológicos que indicaron compromiso de los márgenes quirúrgicos tras la enucleación. Esta modalidad terapéutica combinada ha mostrado cierto potencial en neoplasias agresivas con márgenes infiltrados, al permitir un control locorregional más efectivo del crecimiento tumoral residual. No obstante, en el presente caso, esta opción fue descartada desde el inicio debido a la decisión de la tutora, quien optó por no proseguir con tratamientos complementarios más intensivos.3
Por otro lado, diversos estudios han documentado la expresión del receptor del factor de crecimiento derivado de plaquetas (PDGFR) en algunos casos de SH, lo que sugiere una posible diana terapéutica de interés. Esta expresión ha abierto la puerta a la investigación del uso de inhibidores de tirosina quinasa como estrategia complementaria de tratamiento. En particular, se han descrito respuestas parciales al empleo de masitinib, un inhibidor selectivo de tirosina quinasa, en casos seleccionados, lo que podría representar una línea terapéutica futura a considerar, especialmente en aquellos pacientes con enfermedad residual o recaída local tras tratamiento convencional.3-15
En conclusión, el caso descrito representa un ejemplo poco común de SH ocular localizado en un felino, con un diagnóstico confirmado mediante inmunohistoquímica, destacando la utilidad del marcador CD204. A pesar de la ausencia inicial de metástasis, la evolución clínica posterior sugiere una posible diseminación neurológica, lo que subraya la naturaleza agresiva e infiltrativa de esta neoplasia, incluso en presentaciones aparentemente localizadas. La limitada eficacia de los tratamientos convencionales y la decisión de no implementar terapias complementarias más agresivas condicionaron negativamente el pronóstico. Este caso refuerza la necesidad de considerar al SH en el diagnóstico diferencial de masas orbitarias felinas y plantea la importancia de un abordaje terapéutico multimodal, así como de investigar nuevas estrategias dirigidas, como los inhibidores de tirosina quinasa, para mejorar el manejo y la supervivencia de estos pacientes.
Fuente de financiación: este trabajo no se ha realizado con fondos comerciales, públicos o del sector privado.
Conflicto de intereses: los autores declaran que no existe conflicto de intereses.
Bibliografía
- 1.
Isaza D, Robinson NA, Pizzirani S, Pumphrey SA. Evaluation of cytology and histopathology for the diagnosis of feline orbital neoplasia: 81 cases (2004-2019) and review of the literature. Vet Ophthalmol 2020; 23(4): 682-689.
[PubMed] - 2.
Coall SM, Premont JE, Flatz K, et al. Clinical, advanced imaging data and outcome of inflammatory and neoplastic orbital disease in 81 dogs and 16 cats in Australia (2010-2019). Vet Ophthalmol 2022; 25 Suppl 1: 37-50.
[PubMed] - 3.
Clifford CA, Skorupski KA, Moore PF: Enfermedades histiocíticas. En Vail DM, Thamm DH, Liptak JM (eds): Oncología de pequeños animales, 6ª ed. Zaragoza, Elsevier España, 2020; 607.
- 4.
Scurrell E, Trott A, Rozmanec M, Belford CJ. Ocular histiocytic sarcoma in a cat. Vet Ophthalmol 2013; 16 Suppl 1:173-176.
[PubMed] - 5.
Engelien JL, Lejeune AT, Dark MJ, Milner RJ, Shiomitsu K. RNA in situ hybridisation as a molecular diagnostic technique targeting IBA-1 and CD204 in canine histiocytic sarcoma. Vet Med Sci 2022; 8(4): 1400-1408.
[PubMed] - 6.
Kato Y, Murakami M, Hoshino Y, et al. The class A macrophage scavenger receptor CD204 is a useful immunohistochemical marker of canine histiocytic sarcoma. J Comp Pathol 2013; 148(2-3): 188-196.
[PubMed] - 7.
Ide K, Setoguchi-Mukai A, Nakagawa T, et al. Disseminated histiocytic sarcoma with excessive hemophagocytosis in a cat. J Vet Med Sci 2009; 71(6): 817-820.
[PubMed] - 8.
Takahashi M, Tomiyasu H, Hotta E, et al. Clinical characteristics and prognostic factors in dogs with histiocytic sarcomas in Japan. J Vet Med Sci 2014; 76(5): 661-666.
[PubMed] - 9.
Pinard J, Wagg CR, Girard C, Kiupel M, Bédard C. Histiocytic Sarcoma in the Tarsus of a Cat. Vet Pathol 2006; 43(6): 1014-1017.
[PubMed] - 10.
Moore PF. A review of histiocytic diseases of dogs and cats. Vet Pathol 2014; 51(1): 167-184.
[PubMed] - 11.
Ruppert SL, Ferguson SH, Struthers JD, Jones TL. Oral histiocytic sarcoma in a cat with mandibular invasion and regional lymph node metastasis. JFMS Open Rep 2021; 7(2): 20551169211058044.
[PubMed] - 12.
Néčová S, North S, Cahalan S, Das S. Oral histiocytic sarcoma in a cat. JFMS Open Rep 2020; 6(2): 2055116920971248.
[PubMed] - 13.
Mastrorilli C, Spangler EA, Christopherson PW, et al. Multifocal cutaneous histiocytic sarcoma in a young dog and review of histiocytic cell immunophenotyping. Vet Clin Pathol 2012; 41(3): 412-418.
[PubMed] - 14.
Fan TM, Kitchell BE, Dhaliwal RS, et al. Hematological toxicity and therapeutic efficacy of lomustine in 20 tumor-bearing cats: critical assessment of a practical dosing regimen. J Am Anim Hosp Assoc 2002; 38(4): 357-363.
[PubMed] - 15.
Treggiari E, Ressel L, Polton GA, et al. Clinical outcome, PDGFRβ and KIT expression in feline histiocytic disorders: a multicentre study. Vet Comp Oncol 2017; 15(1): 65-77.
[PubMed]